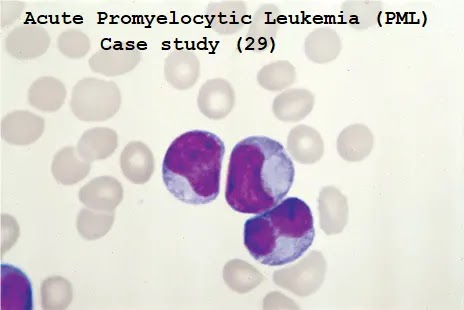
Hematology case studies with answers pdf image

Are you searching for 'apl case study'? Here you can find all of the details.
Case Study The identifying chromosomal abnormality related with APL is t (15;17) which is identified stylish ~90% of cases. This translocation results in the coalition of promyelocytic leukaemia (PML) and the retinoic acid sensory receptor alpha (RARA) protein.
Table of contents
- Apl case study in 2021
- Hematopathology case studies
- Case studies in hematology and coagulation pdf
- Acute myeloid leukemia case study pdf
- Hematology case studies ppt
- Complete blood count case studies
- Aml case study examples
- Hematology case studies with answers pdf
Apl case study in 2021
 This picture demonstrates apl case study.
This picture demonstrates apl case study.
Hematopathology case studies
 This image shows Hematopathology case studies.
This image shows Hematopathology case studies.
Case studies in hematology and coagulation pdf
 This image representes Case studies in hematology and coagulation pdf.
This image representes Case studies in hematology and coagulation pdf.
Acute myeloid leukemia case study pdf
 This image illustrates Acute myeloid leukemia case study pdf.
This image illustrates Acute myeloid leukemia case study pdf.
Hematology case studies ppt
 This image representes Hematology case studies ppt.
This image representes Hematology case studies ppt.
Complete blood count case studies
 This picture representes Complete blood count case studies.
This picture representes Complete blood count case studies.
Aml case study examples
 This image shows Aml case study examples.
This image shows Aml case study examples.
Hematology case studies with answers pdf
This picture shows Hematology case studies with answers pdf.
This picture shows Hematology case studies with answers pdf.
How is qPCR used in acute promyelocytic leukemia?
Because the classic t (15;17) translocation creates two fusion genes from one splice, 70% of cases with translocation, harbor a RARA/PML gene, and 100% show the reciprocal PML/RARA gene. 2 This makes qPCR a useful assay for disease screening. Treatment of acute promyelocytic leukemia is unique and involves a combination regimen.
How are cases of apl confirmed in the laboratory?
Cases of APL with t (15;17) are confirmed through laboratory testing and bone marrow observations combined with molecular techniques. Cellular antigenic profiles and chromosomal and genetic mapping are important in determining cells that have the abnormal fusion transcript.
What are the survival rates for APL patients?
The PML/RARA or variant version of a RARA fusion protein not only blocks binding of retinoic acid to its receptor but also activates genes that aid in cell self-renewal. 1,2 Survival rates for patients diagnosed with APL with t (15; 17) are good.
Last Update: Oct 2021